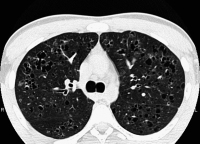
Abbildung 3: Pulmonale Langerhanszell-Histiozytose

| Scheidl S | ||||||||||||||||||||||
|---|---|---|---|---|---|---|---|---|---|---|---|---|---|---|---|---|---|---|---|---|---|---|
|
Mit Inhalation von Zigarettenrauch assoziierte interstitielle Lungenerkrankungen
Journal für Pneumologie 2015; 3 (1): 4-10 Volltext (PDF) Summary Abbildungen
|
||||||||||||||||||||||

Verlag für Medizin und Wirtschaft |
|
||||||||
|
Abbildungen und Graphiken
|
|||||||||
| copyright © 2000–2026 Krause & Pachernegg GmbH | Sitemap | Datenschutz | Impressum | |||||||||
|
|||||||||